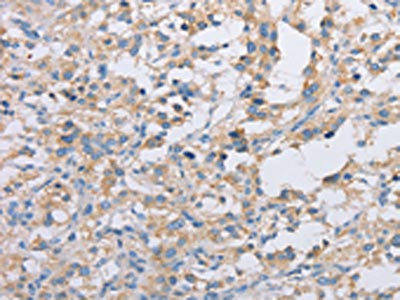

ACTR2 Antibody
-
中文名稱:ACTR2兔多克隆抗體
-
貨號:CSB-PA102745
-
規格:¥1100
-
圖片:
-
其他:
產品詳情
-
Uniprot No.:
-
基因名:
-
別名:Actin like protein 2 antibody; Actin related protein 2 antibody; Actin-like protein 2 antibody; Actin-related protein 2 antibody; ACTR2 antibody; ARP2 actin related protein 2 homolog (yeast) antibody; ARP2 antibody; ARP2/3 COMPLEX antibody; ARP2_HUMAN antibody; OTTHUMP00000159937 antibody; OTTHUMP00000202270 antibody
-
宿主:Rabbit
-
反應種屬:Human,Mouse,Rat
-
免疫原:Fusion protein of Human ACTR2
-
免疫原種屬:Homo sapiens (Human)
-
標記方式:Non-conjugated
-
抗體亞型:IgG
-
純化方式:Antigen affinity purification
-
濃度:It differs from different batches. Please contact us to confirm it.
-
保存緩沖液:-20°C, pH7.4 PBS, 0.05% NaN3, 40% Glycerol
-
產品提供形式:Liquid
-
應用范圍:ELISA,IHC
-
推薦稀釋比:
Application Recommended Dilution ELISA 1:2000-1:5000 IHC 1:25-1:100 -
Protocols:
-
儲存條件:Upon receipt, store at -20°C or -80°C. Avoid repeated freeze.
-
貨期:Basically, we can dispatch the products out in 1-3 working days after receiving your orders. Delivery time maybe differs from different purchasing way or location, please kindly consult your local distributors for specific delivery time.
-
用途:For Research Use Only. Not for use in diagnostic or therapeutic procedures.
相關產品
靶點詳情
-
功能:ATP-binding component of the Arp2/3 complex, a multiprotein complex that mediates actin polymerization upon stimulation by nucleation-promoting factor (NPF). The Arp2/3 complex mediates the formation of branched actin networks in the cytoplasm, providing the force for cell motility. Seems to contact the pointed end of the daughter actin filament. In podocytes, required for the formation of lamellipodia downstream of AVIL and PLCE1 regulation. In addition to its role in the cytoplasmic cytoskeleton, the Arp2/3 complex also promotes actin polymerization in the nucleus, thereby regulating gene transcription and repair of damaged DNA. The Arp2/3 complex promotes homologous recombination (HR) repair in response to DNA damage by promoting nuclear actin polymerization, leading to drive motility of double-strand breaks (DSBs).
-
基因功能參考文獻:
- We speculate that ACTR2 and MEIS1 might respectively play a role in the pathogenesis of the observed deafness and cardiomyopathy...the patient carrying a 2p14p15 deletion including OTX1 had normal kidneys and genitalia, thus confirming that OTX1 haploinsufficiency is not invariably associated with genitourinary defects. PMID: 28599093
- this study identified roles for ARP2 and filopodia in human respiratory syncytial virus -induced cell motility, virus production, and cell-to-cell spread. PMID: 27926942
- Coronin3 can regulate gastric cancer (GC) invasion and metastasis through Arp2, and the combination of Coronin3 and Arp2 provides a potential marker for predicting GC prognosis. PMID: 24918434
- Neural Wiskott-Aldrich syndrome protein (N-WASP)-mediated p120-catenin interaction with Arp2-Actin complex stabilizes endothelial adherens junctions. PMID: 23212915
- Using molecular dynamics simulations and biochemical assays with recombinant Arp2/3 complex, we now show how phosphorylation of Arp2 induces conformational changes permitting activation. PMID: 22125478
- ARP2-mediated actin polymerization is regulated by phosphorylation of WASP protein. PMID: 12791263
- Coexpression of Arp2 and WAVE2 is correlated with poorer patient outcome. PMID: 16638851
- High mRNA levels of Arp2 were significantly associated with liver metastasis of colorectal cancer. PMID: 17459058
- Arp2-depleted Jurkat T lymphocytes exhibit defects in spreading on anti-CD3; Arp2-depleted Jurkats exhibit defects in ruffle assembly but not in assembly of mitotic linear protrusions. PMID: 18720401
顯示更多
收起更多
-
亞細胞定位:Cytoplasm, cytoskeleton. Cell projection. Nucleus.
-
蛋白家族:Actin family, ARP2 subfamily
-
數據庫鏈接:
Most popular with customers
-
-
YWHAB Recombinant Monoclonal Antibody
Applications: ELISA, WB, IHC, IF, FC
Species Reactivity: Human, Mouse, Rat
-
Phospho-YAP1 (S127) Recombinant Monoclonal Antibody
Applications: ELISA, WB, IHC
Species Reactivity: Human
-
-
-
-
-